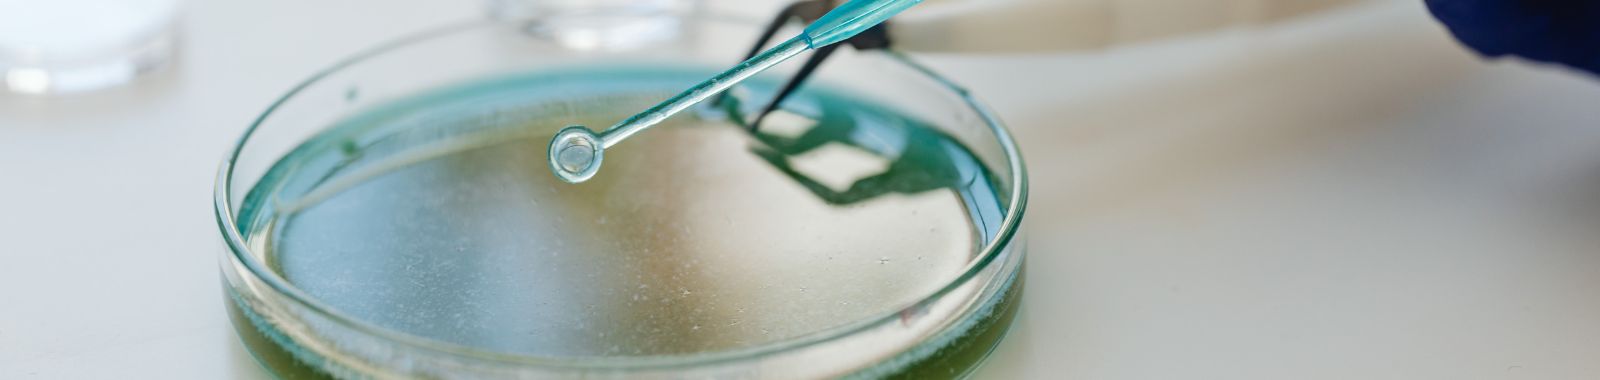

Beyond the Buzzword: How to Validly Claim Your Product Is Microbiome-Friendly
Global expertise, personal touch
Interest in microbiome-aware beauty, personal care, and wellness products has been increasing rapidly. As consumers become increasingly conscious of the microorganisms present in the skin, scalp, oral, vaginal, and gut ecosystems, the concept of a microorganism-friendly brand is becoming more commonly used in packaging, online communication, and product narratives.
Even though the term is quite attention-grabbing and in line with current scientific trends, there is a complexity to the issue. The statement might be unclear, confusing, or non-conforming in the absence of adequate evidence to support it, leaving brands vulnerable to regulatory and reputational losses. Thus, it is essential to make, validate, and responsibly convey microbiome-friendly claims.
What does "microbiome-friendly" really mean?
In this context, being microbiome-friendly may be used to describe a product that has been verified and substantiated to maintain, support, or be non-disruptive to microbiome composition, diversity, and performance under normal conditions of use. Notably, these assertions go beyond the ingredient list. Even a formulation containing gentle, natural, or plant-based materials could harm commensal microbes, depending on concentration, preservation method, or pH profile. In this regard, microbiome compatibility should always be established for the finished product, not based on assumptions or ingredient history.
"Microbiome-friendly" is not necessarily therapeutic or a permanent biological transformation; this distinction is vital to prevent misunderstanding. Any suggestion to cure or alter health outcomes requires additional regulatory approvals and official clinical justification. This is aimed at accuracy, transparency, and trust for the end consumer as well as for those who will be scrutinising the regulatory reviews.
Evidence required for a validated microbiome-friendly claim
Brands should adhere to evidence-based standards in making a microbiome-friendly statement. Appropriate substantiation forms include, but are not restricted to:
- In vitro microbiome testing of the growth responses of appropriate commensal microorganisms compared to those of pathogens.
- Metagenomic sequencing of the modification in microbiome composition before and after use.
- Microbiome safety testing to assess whether a product disturbs or suppresses the natural microbial ecosystem.
- Outcomes of clinical microbiome studies that have associated user experience and changes in the microbiome surface environment.
- The presence of antimicrobial activity of the formulation at in-use concentration, when not intended.
It is crucial to balance microbiome claims with mandatory safety assessments. Brands must engage a qualified antimicrobial efficacy testing lab to ensure formulas remain safe without being overly aggressive. This involves conducting a standard antimicrobial efficacy test (often abbreviated as antimicrobial efficacy testing, AET).
Whether following an antimicrobial efficacy test protocol based on the antimicrobial efficacy test USP or antimicrobial efficacy test EP standards, the chosen antimicrobial efficacy test method must be compatible with the product type. For specific regulatory needs, EPA antimicrobial efficacy testing may also be required.
While internal teams may review an antimicrobial efficacy test ppt for training, valid validation requires rigorous antimicrobial effectiveness and preservative efficacy testing. Specifically, the antimicrobial preservative efficacy test determines if the preservation system is effective yet distinct from the product's microbiome-friendly properties.
The testing should represent authentic use, including exposure time, product type (rinse-off or leave-on), target area, and probable consumer trends. For instance, the same protocol cannot be used when testing a scalp serum as when testing a rinse-off hand cleanser. Accuracy is important in the end product: a defensible claim of microbiome compatibility.
Evidence cannot be derived solely through natural or gentle formulas. Similarly, ingredient-only testing fails to affirm the finished product. The regulatory expectations also focus on the demonstrated performance of the entire formulation, which is the only form the consumer will actually utilise.
Scientific communication requirements
A significant challenge is data generation and communication. If a statement relates to the microbiome, the wording should indicate the precise strength of the evidence. Here are examples of improper and compliant communication:
|
Not Recommended |
Recommended |
|
“Boosts the microbiome and protects against bad bacteria.” |
“Shown in controlled testing to be non-disruptive to microbiome diversity.” |
|
“Repairs damaged microbiome and supports immunity.” |
“Validated through microbiome safety testing to maintain microbial balance when used as directed.” |
The aim is not to diminish the importance of the findings, but to depict them in a scientifically accurate, open, and impartial way. Giving out too many promises may lead to a risky situation, while being clear in your communication increases your trustworthiness.
Communication checklist for internal teams
Every microbiome-friendly claim should be checked against the following checklist to ensure consistent and responsible messaging:
- Is the claim based on microbiome in vitro testing, sequencing, or a clinical microbiome study and not on ingredient assumptions?
- Was the product tested on the correct microbiome site (skin, scalp, vaginal, oral, gut)?
- Is the consumer-facing wording of the claim in line with the level of evidence?
- Can the methodology be provided if an auditor or regulator requests it?
- Does the communication refrain from suggesting the usage of the product for the treatment of diseases?
- Have cross-functional teams — including R&D, Regulatory Affairs, and Scientific Communications — reviewed the terminology?
Communication should be understandable to the general public and, at the same time, maintain scientific integrity. Scientific high-quality evidence presented realistically is more trustworthy than exaggerated benefits.
Recommended development workflow for microbiome-focused products.
It is highly efficient for both creation and communication if the intended claim is defined at the very beginning of the development process. The example of the typical workflow is as follows:
- Claim intent set during early formulation design
- Initial in vitro microbiome tests are done to quickly rule out any possible disruptions before scaling up
- If there are compatibility issues, the preservation, pH, and surfactant system are adjusted
- Performing microbiome safety testing or a clinical microbiome study with the final formula
- Considering communication and regulatory guidelines while reviewing claim language
- Using packaging and digital materials for the implementation of compliant messaging
If the evaluation is started too late, i.e., after packaging approval or regulatory submission, the risk, cost, and delay are increased substantially. It is easier for the execution to be done when there is an agreement between lab teams and communication stakeholders from the very beginning.
Misconceptions frequently encountered
Several assumptions are still widely accepted by the industry. The most frequent ones are:
|
Misconception |
Why It Poses Risk |
|
“Natural products are automatically microbiome-friendly.” |
Some natural ingredients exhibit antimicrobial effects. Compatibility must be proven objectively. |
|
“If a competitor claims it, we can claim it.” |
Competitive comparisons cannot justify claims. Substantiation must be independent. |
|
“If consumers like it, it must support the microbiome.” |
Subjective feedback does not equate to validated microbial safety. |
|
“Preservative-free equals microbiome-friendly.” |
Absence of a preservative does not guarantee safety or compatibility. Improper microbial control can compromise both product and user. |
A defensible strategy involves following a communication path driven by data rather than assumptions.
Tone, readability, and responsibility
Claims about the microbiome are a complex issue that lies at the confluence of science, regulation, and marketing. The communication approach should be:
- Precision
- Transparency
- Avoidance of over-interpretation
- Respect for ongoing scientific discovery
When a product is certified as microbiome-friendly, expressing this correctly will be helpful to consumers and increase trust in the brand. Nevertheless, in the long term, there is a risk of maintaining silence when the data are weak or inconclusive. Responsible communication is not a matter of choice; it is a strategic asset.
Conclusion
The increase in demand for products that are safe, backed by science, and friendly to the microbiome underscores the importance of rigorous validation. As a result, brands that back up their claims with open, defensible data, moving from in vitro assays to clinical microbiome compatibility studies, will not only reduce regulatory risk but also increase consumer trust and brand equity over time. There is no internal assumption that can be replaced by independent testing, which adds credibility to some extent.
For a company seeking to complete the entire microbiological validation process, which includes microbiome safety testing, preservative efficacy studies, challenge testing, and clinical microbiome compatibility assessment, companies of the Eurofins network offer specialised expertise to beauty, personal care, and wellness formulations. Their state-of-the-art microbiology services have been developed to assist formulators in introducing products with proven claims that align with consumer expectations and regulatory requirements.
Frequently Asked Questions
- What does “microbiome-friendly” mean for a product?
A microbiome-friendly product is one that has been verified through appropriate testing to be non-disruptive to the natural balance, diversity, and function of the microbiome under normal conditions of use. This means it maintains microbial harmony rather than eliminating or altering beneficial microorganisms. - Is using natural or gentle ingredients enough to claim microbiome compatibility?
No. The presence of natural or gentle ingredients alone does not guarantee microbiome compatibility. Some natural substances may still exhibit antimicrobial effects. Claims must be substantiated through testing of the final finished formulation, not solely based on ingredient history. - What types of testing support a valid microbiome-friendly claim?
Valid claims should be supported by scientific evidence, such as in vitro microbiome testing, metagenomic sequencing, microbiome safety assessments, and clinical microbiome studies. These tests evaluate whether the product maintains microbial balance without disrupting beneficial microorganisms. - Can microbiome-friendly claims imply health or therapeutic benefits?
No. Microbiome-friendly claims should not suggest the treatment, prevention, or cure of diseases. Any therapeutic implications require additional regulatory approval and clinical substantiation to remain compliant. - How should brands communicate microbiome-friendly claims to consumers?
Brands should use precise, transparent, and evidence-aligned language that reflects the level of scientific validation. Claims should avoid exaggeration and be supported by accessible methodologies, ensuring clarity, accuracy, and regulatory compliance.